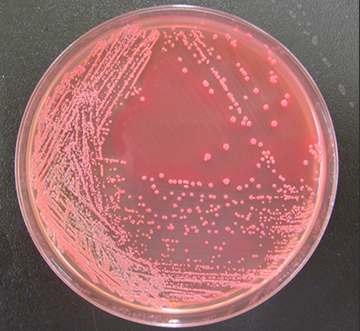

ここから本文です。

感染症部は、食中毒や感染症の集団発生時に緊急の検査を行い、患者や食品から検出された腸管出血性大腸菌(O157等)、ノロウイルス等について遺伝子レベルの解析で感染源・感染経路を究明し、その後の流行防止に役立てています。
また、感染症法に基づき、感染症の患者発生を日常的に把握する「感染症発生動向調査」として、兵庫県感染症情報センターの運営と病原微生物(インフルエンザウイルス、その他のウイルス及び細菌)の検査業務を行っています。
| 試験検査業務 | 概要 |
|---|---|
|
結核菌の試験検査 |
結核予防事業の一環として、県内で分離された結核菌の遺伝子型別及び薬剤感受性試験を実施する。また、結核集団感染事例について、濃厚接触者等のインターフェロンγ遊離試験を実施する。 |
| 腸管出血性大腸菌の試験検査 | 県内で分離された腸管出血性大腸菌について、毒素試験や血清型別、遺伝子検査を実施する。 |
| 薬剤耐性菌の試験検査 | 患者由来のカルバペネム耐性腸内細菌科細菌やバンコマイシン耐性腸球菌等の菌株について、耐性遺伝子の検出及び表現型検査を実施する。 |
| 呼吸器感染症起因菌の試験検査 | 県内で分離された肺炎球菌や百日咳菌等の菌株について、薬剤感受性試験、血清型別等を実施する。 |
| 細菌、寄生虫による集団感染及び食中毒(疑)事例の感染源調査 | 集団感染事例及び食中毒疑い事例の患者や環境から分離された腸管出血性大腸菌、黄色ブドウ球菌やサルモネラ属菌等の食中毒原因菌について、表現型検査や遺伝子検査、型別等を行う。K.septempunctataなど食中毒の原因となる一部寄生虫についても検査を実施する。 |
| 輸入ナチュラルチーズのリステリア菌検査 | 市場に流通している輸入ナチュラルチーズについて、Listeria monocytogenesの検査を実施する。 |
| 蚊媒介感染症の検査 | デング熱、チクングニア熱、ジカウイルス感染症等、蚊媒介感染症が疑われる患者を対象に、ウイルスの遺伝子検査を実施する。 |
| ダニ媒介感染症の検査 | 日本紅斑熱、ツツガムシ病、重症熱性血小板減少症候群(SFTS)等、ダニ媒介感染症が疑われる患者を対象に、リケッチア及びウイルスの遺伝子検査等を実施する。 |
| 新型コロナウイルスの検査 | 新型コロナウイルス感染症が疑われる患者検体について、新型コロナウイルスの遺伝子検出、変異株サーベイランス及びゲノム解析を行う。 |
| 肝炎ウイルスの検査 | ウイルス性肝炎が疑われる患者について、A型またはE型肝炎ウイルスの遺伝子検査を実施する。 |
| HIVの確認検査 | エイズ蔓延を防止するために、健康福祉事務所(保健所)で行うスクリーニング検査が陽性となった検体について、HIVの抗体検出等の確認検査を実施する。 |
| 麻しんウイルス・風しんウイルスの検査 | 麻しんまたは風しんが疑われる患者検体について、麻しんウイルスと風しんウイルスの遺伝子検査を実施する。 |
| 食品のノロウイルス検査 | 食品衛生対策の一環として、市販生食用かきのノロウイルスの遺伝子検査を実施する。 |
| 集団感染及び食中毒(疑)事例のウイルス検査 | インフルエンザ感染を疑う患者の集団発生事例について、インフルエンザウイルスの分離や遺伝子検査を実施する。嘔吐下痢症等の食中毒が疑われる事例において、ノロウイルス等の遺伝子検査等を実施し、原因病原体や感染ルートを解明する。 |
| 新型インフルエンザウイルス系統調査・保存事業(厚生労働省への協力事業) | 新型インフルエンザウイルスの迅速なワクチン生産や検査キットの供給を可能にすることを目的として、県内に飛来する水鳥の糞便から鳥インフルエンザウイルスの分離を行う。 |
| 厚生労働省感染症流行予測調査 | 疾病の流行予測を目的として、ブタの日本脳炎の血清抗体価の測定や、患者あるいはブタの検体についてインフルエンザウイルス、ロタウイルス、肺炎球菌の分離、遺伝子検査等を実施する。 |
| 病原体サーベイランスにおける病原体検索 | インフルエンザ及び小児科定点医療機関で採取された患者検体について、インフルエンザウイルス、アデノウイルス、エンテロウイルス等の病原体検査及び型別等を行い、県内の流行状況を把握する。 |
| 感染症情報の提供と情報分析 | 基幹地方感染症情報センターとして、政令市を含む県下の医療機関からの感染症情報を分析し、病原体情報と併せて週報・月報を発行し、健康福祉事務所、保健所、市町、医師会、医療機関等に還元するとともに、ホームページに掲載して広く県民に公開する。 |
| インフルエンザ情報センターからの情報提供 | インフルエンザに関する情報を一元的に管理提供するため、学校サーベイランス、医療機関情報及び広域・救急医療情報の3つのシステムのポータルサイトを感染症情報センターホームページ上に設け、感染症発生動向調査情報との一体的な情報提供を図っている。 |
お問い合わせ